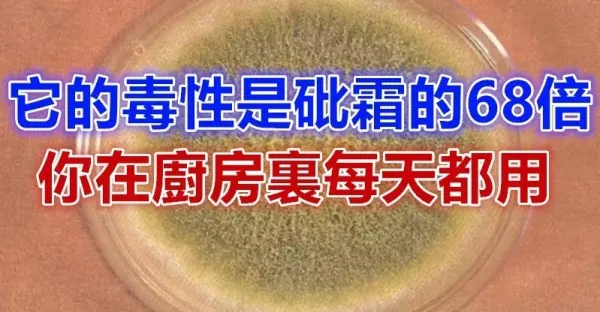

任我行 • 3K次觀看

任我行 • 310次觀看

開心果 • 550次觀看

開心果 • 70K次觀看

開心果 • 1K次觀看

任我行 • 900次觀看

呂純弘 • 460次觀看

呂純弘 • 140次觀看

開心果 • 680次觀看

開心果 • 32K次觀看

開心果 • 7K次觀看

任我行 • 46K次觀看

呂純弘 • 273K次觀看

任我行 • 121K次觀看

開心果 • 690次觀看

任我行 • 810次觀看

呂純弘 • 370次觀看

任我行 • 20K次觀看

呂純弘 • 700次觀看

開心果 • 1K次觀看

開心果 • 2K次觀看

房香青 • 610次觀看

房香青 • 680次觀看

房香青 • 3K次觀看